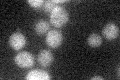
YOL039W
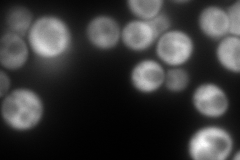
YOL039W
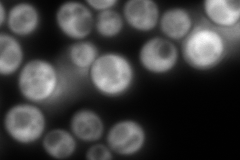
YOL039W

View description
Ribosomal protein P2 alpha, a component of the ribosomal stalk, which is involved in the interaction between translational elongation factors and the ribosome; regulates the accumulation of P1 (Rpp1Ap and Rpp1Bp) in the cytoplasm
Localization:
Intensity:
Fold change:
Significance:
-
C’ GFP library in SD
below threshold16.63 -
N' NOP1pr-GFP in SD

cytosol279.946 -
N' TEF2pr-mCherry in SD
cytosol562.912 -
N' NATIVEpr-GFP in SD
cytosol969.258 -
N' TEF2pr-VC and Cyto-VN in SD

#N/A0 -
C’ GFP library in SD+DTT

cytosol16.751No -
C’ GFP library in SD+H2O2

cytosol17.211.03No -
C’ GFP library in Starvation Media

cytosol19.271.15No -
C’ GFP library on the background of Pup2-DaMP

below threshold -
C’ GFP library on the background of CCT mutant

below threshold27.56541.65677Yes
